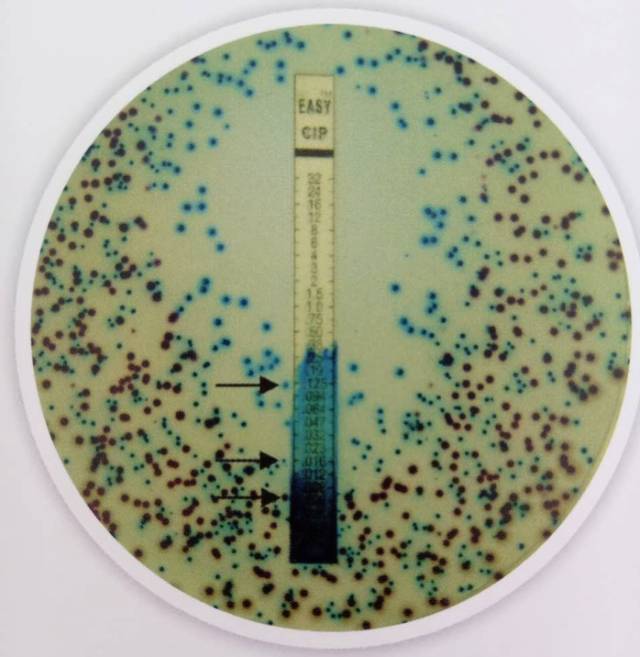
HiCrome™显色培养基快速鉴定细菌，已在国际悄然流行！
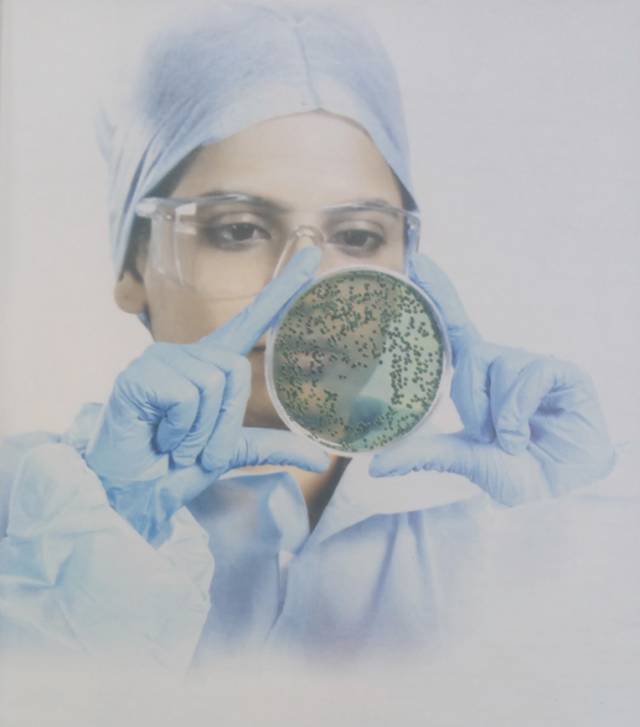
HiCrome™显色培养基快速鉴定细菌，已在国际悄然流行！

9 年
手机商铺
公司新闻/正文
136 人阅读发布时间:2017-11-09 16:24
人类的生产和生活环境经常被微生物污染。许多行业如食品、药品、化妆品、医院都需要对微生物进行检测。

但微生物种类繁多,日益复杂,一些新的耐药菌也不断出现。
因此,只有发展各种微生物的检测技术,尽快检测出各种具有潜在致病性的微生物,才能有效地预防和控制各种微生物感染。
传统方法检测和鉴定微生物,虽然成本较低,但需要时间较长,而且特异性不高,必须进行补充试验,才能区分菌落形态相似的干扰菌,才能最后报告结果。
近十年兴起了显色培养基。它将微生物的分离与鉴定合二为一,省时省力,操作简便,敏感性和特异性都较高,在培养之前也不需要增菌,因此具有巨大的优势。
图. HiMedia公司生产的HiCrome™显色培养基Mueller Hinton琼脂鉴定的尿道病原菌。传统方法需48小时。该方法只需24小时。
其原理是根据每种微生物所包含的酶及反应条件,作为微生物分类鉴定的重要依据。
显色培养基一般是在分离培养基中加入检测某些菌种的特异性酶底物。该底物由产色基团和微生物可代谢物质组成,通常为无色。但在特异性酶作用下游离出发色基团并显示一定颜色,直接观察菌落颜色即可对菌种做出鉴定。
有些显色培养基加有抑制杂菌生长的物质,因而特异性大大提高。
显色培养基通常为干粉状,容易保存。加蒸馏水溶解后,也无须高压灭菌,煮沸即可倒平板,划线接种,置适宜温度下培养一定时间即可。培养时间依具体培养基而定,通常是18-24小时,比传统时间显著缩短。

图. 采用HiMedia公司HiCrome™ MRSA琼脂培养基鉴别培养的耐甲氧西林表皮葡萄球菌(右)和金黄色葡萄球菌(左)
HiMedia Laboratories作为世界顶尖的微生物产品生长商,提供有众多以HiCromeTM为开头命名的显色培养基。
和法国Chromagar、德国Merck、英国Oxoid、美国Remel其他显色培养基厂家比较,HiMedia显色培养基产品更丰富,而且常用的培养基由植物源性蛋白成分或化学限定成分组成,性能等于或优于动物源性产品,安全性却更高,避开疯牛病风险和转基因植物风险,同时也具有更高的可重复性。
相信随着技术的发展,会有越来越多的显色培养基出现,从而能快速筛选和检测病原菌,为保证产品质量和食品安全、监测环境、控制院内感染和指导合理用药,做出更多的贡献。
HiMedia Laboratories公司简介

HiMedia是全球顶尖的微生物产品供应商,拥有世界高技术的生产工艺,提供有种类丰富的微生物培养基,包括颗粒培养基、植物源性培养基(HiVeg™)、化学限定培养基(HiCynth™)和显色培养基(HiCrome™)等。HiMedia拥有自己的大型原料生产工厂,产品生产均通过了ISO9001、ISO13485、WHO-GMP认证、CE认证和FDA认证,满足各个领域的精准需求。